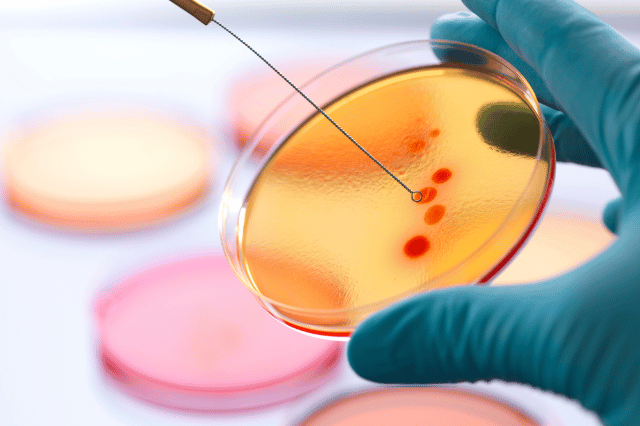
pathology lab in hinjewadi

PATHOLOGY LAB
Best Pathology Lab in Punawale Pune
Best Pathology Lab in Punawale - Medilife Superspeciality Clinic Punawale Pune-When it comes to healthcare, accuracy and reliability are of utmost importance. This is especially true when it comes to pathology labs, where accurate diagnosis plays a crucial role in determining the right treatment plan for patients. In Punawale, Pune, one pathology lab stands out for its commitment to excellence - Medilife Superspeciality Clinic.
Medilife Superspeciality Clinic is renowned for its state-of-the-art facilities and advanced diagnostic services. With a team of highly skilled and experienced pathologists, they are dedicated to providing accurate and timely results to their patients. Their commitment to quality has earned them the reputation of being the best pathology lab in Punawale.